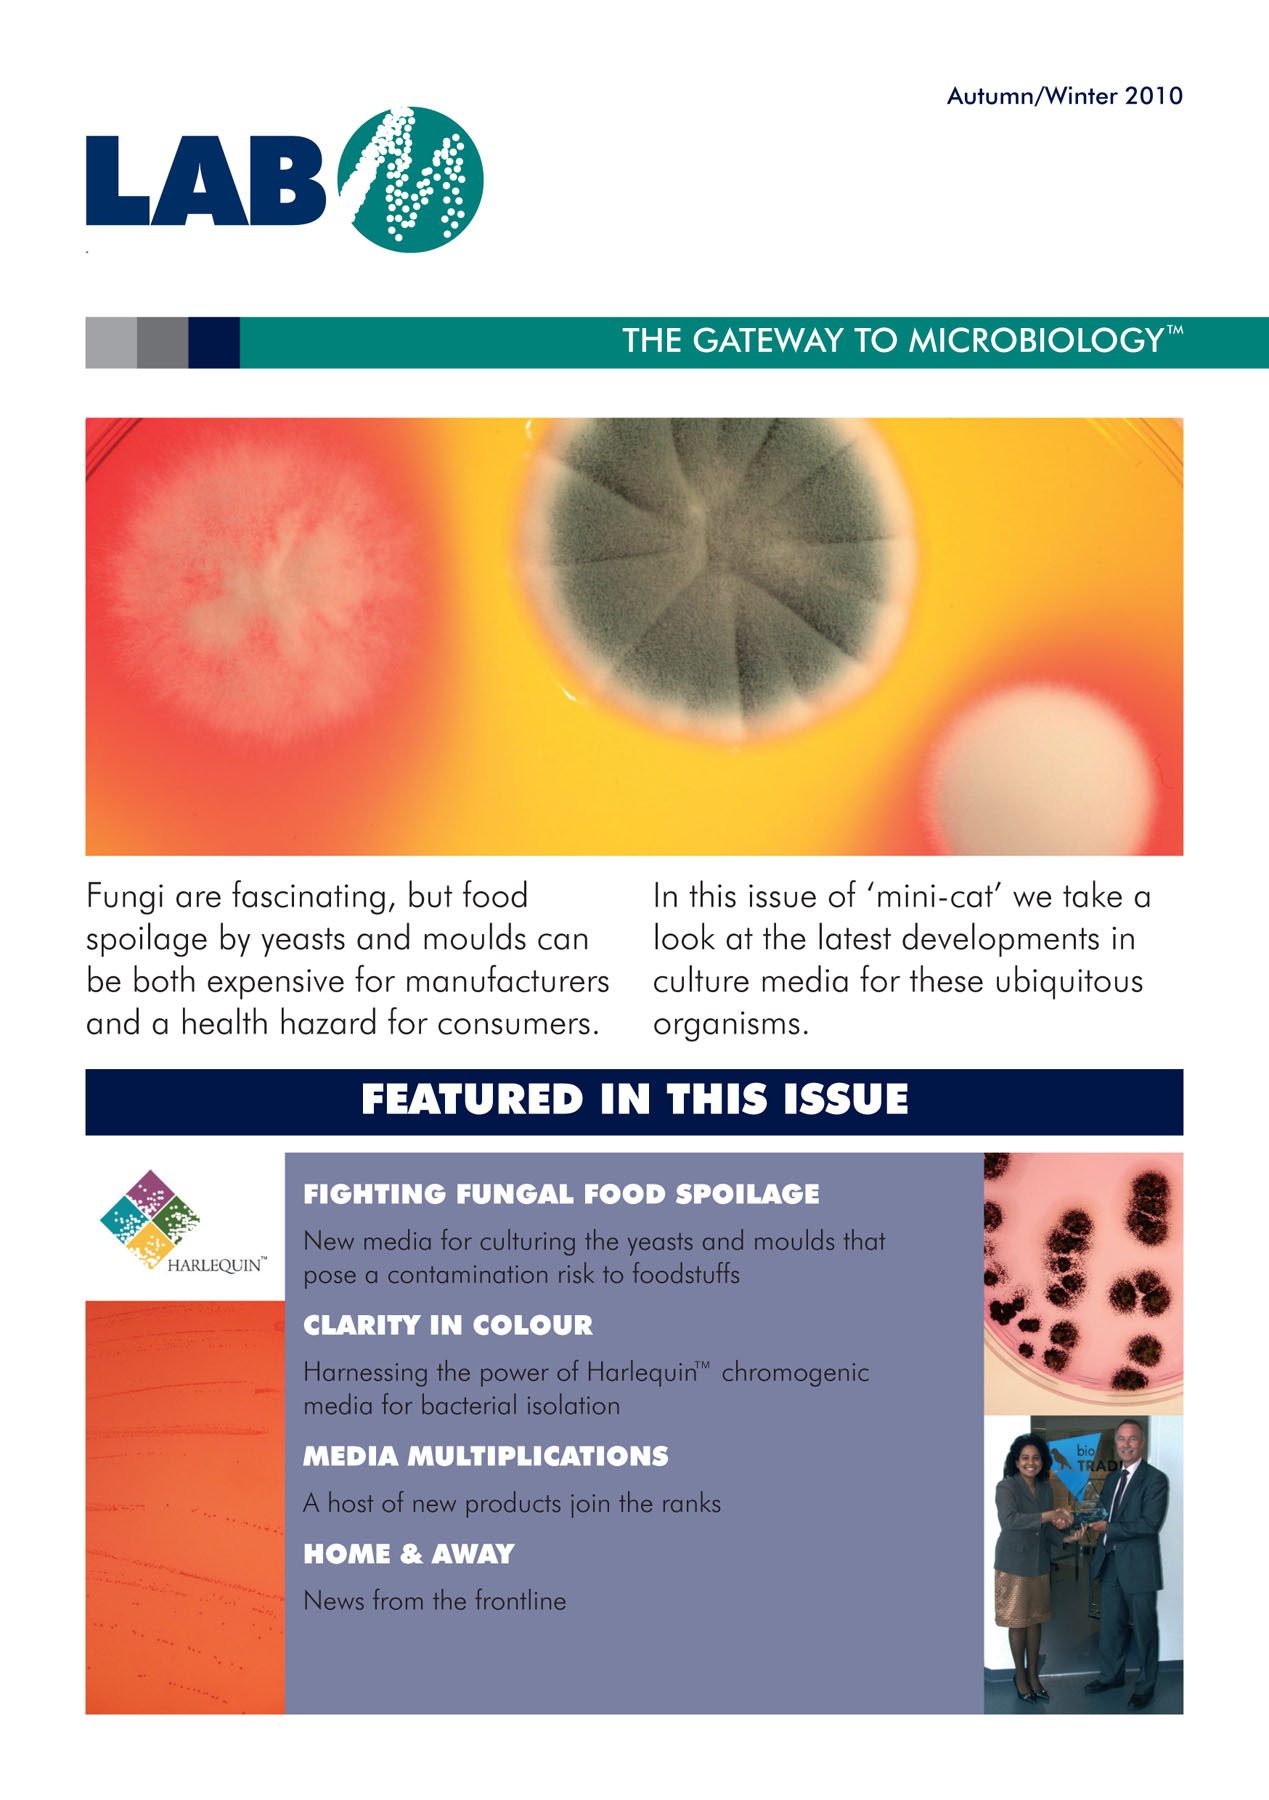

Channels
Special Offers & Promotions
Hotter than a Christmas mince pie! New Lab M Mini Catalogue now Available
Hot off the press, the Autumn/Winter 2010 issue of Lab M's mini-cat is now available, and it's free! Packed with features, news and the latest microbiology product information, this 8-page issue is yours by simply mailing info@labm.com. Tell us if you'd like the print edition or prefer to receive it electronically.
Hot off the press, the Autumn/Winter 2010 issue of Lab M's mini-cat is now available, and it's free! Packed with features, news and the latest microbiology product information, this 8-page issue is yours by simply mailing info@labm.com. Tell us if you'd like the print edition or prefer to receive it electronically.
Fascinating fungi - or more correctly, how to culture yeasts and moulds in the fight against food spoilage - is one of the main topics. You can also learn about a decade of development for Lab M's HarlequinTM chromogenic media, and in particular about the ISO formulations and their applications for the food industry; a new addition to the MacConkey agar family; a Staphylococcus aureus enrichment broth; and a new anaerobe medium for culturing Clostridia.
Email now to request your copy info@labm.com
Media Partners


